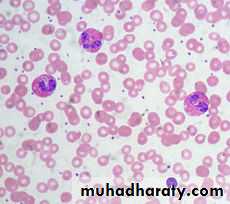
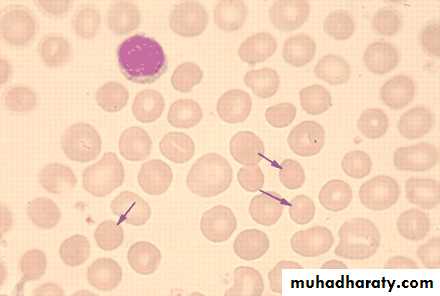
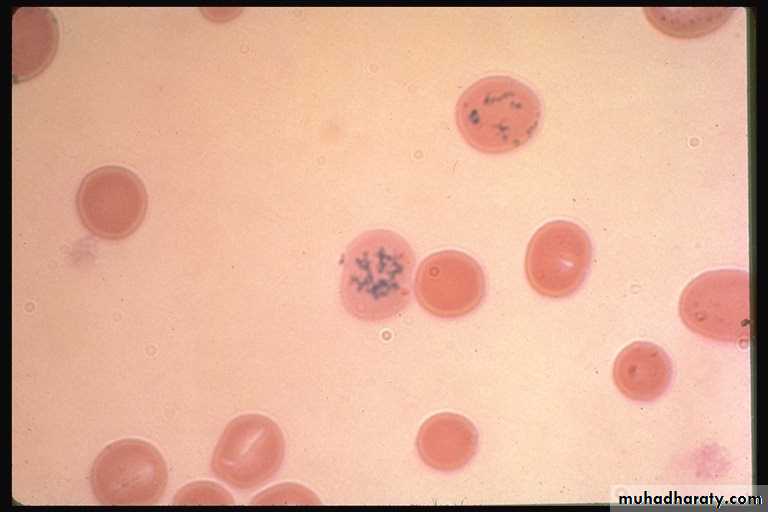
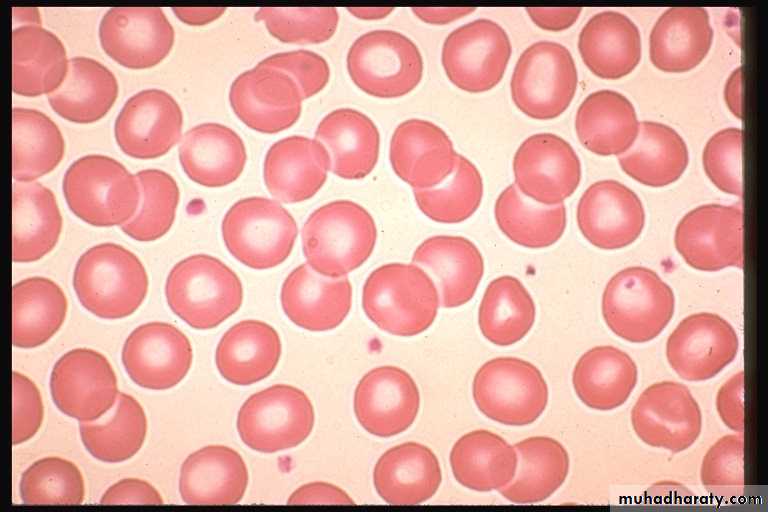
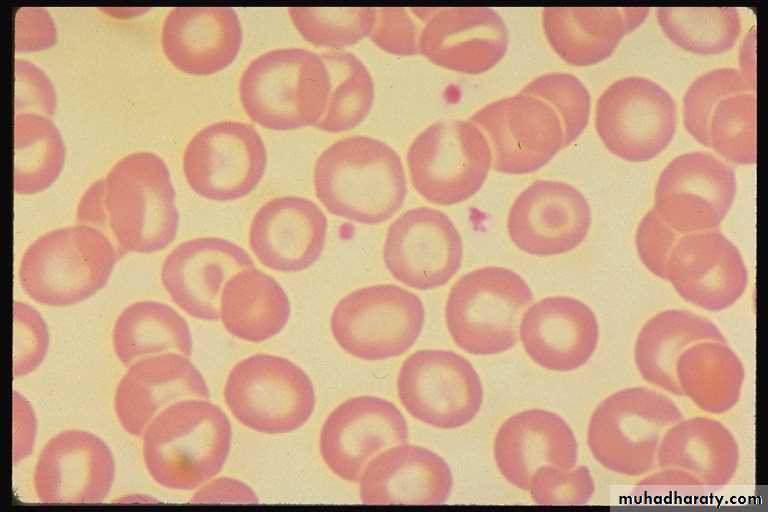
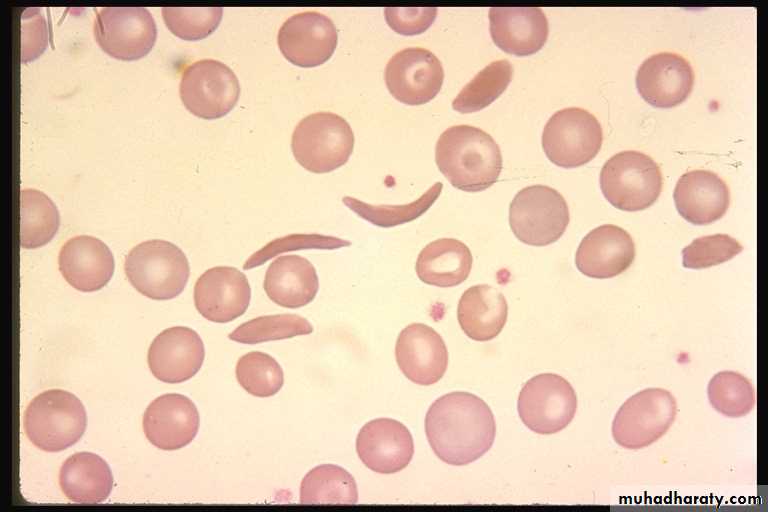
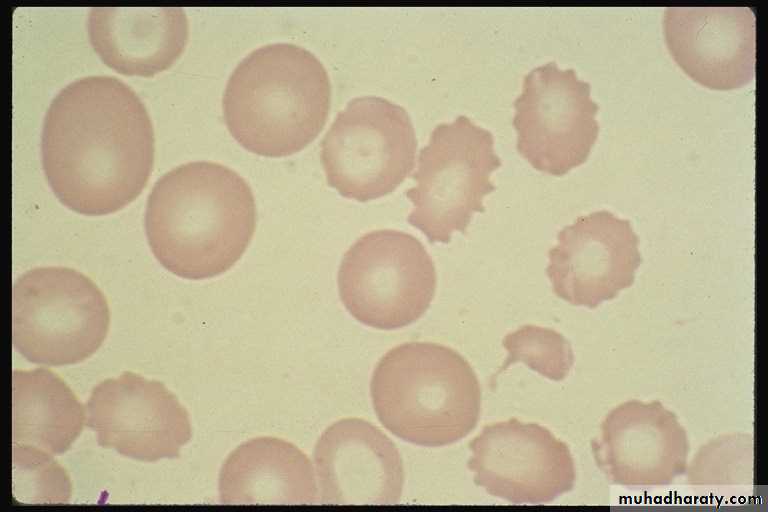
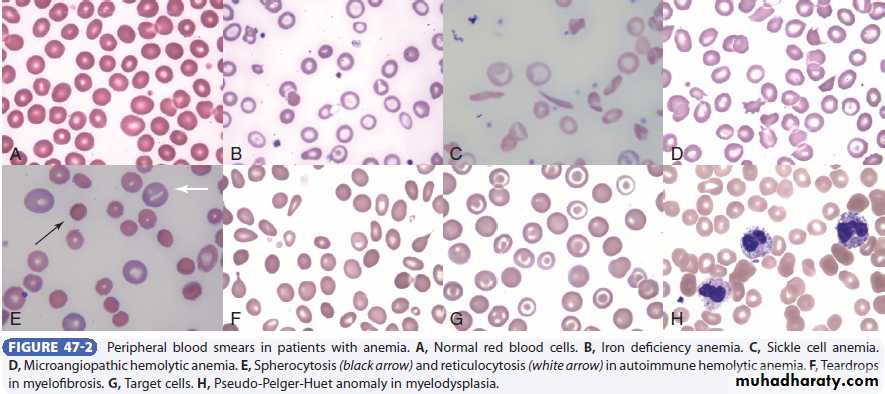
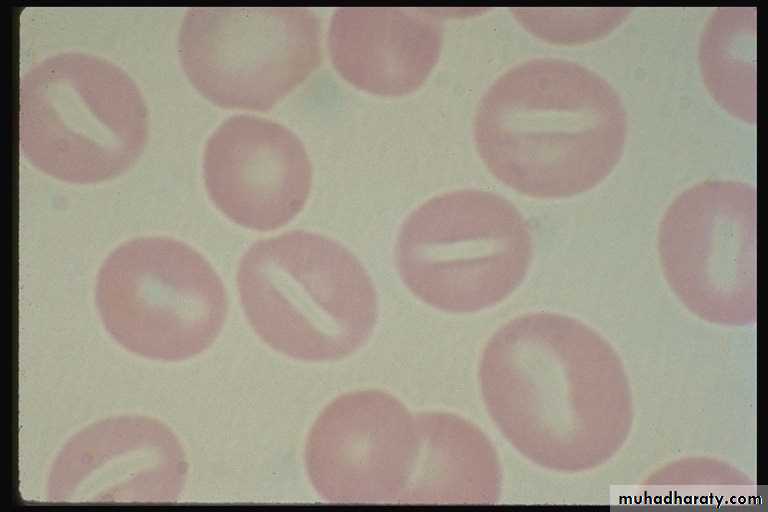
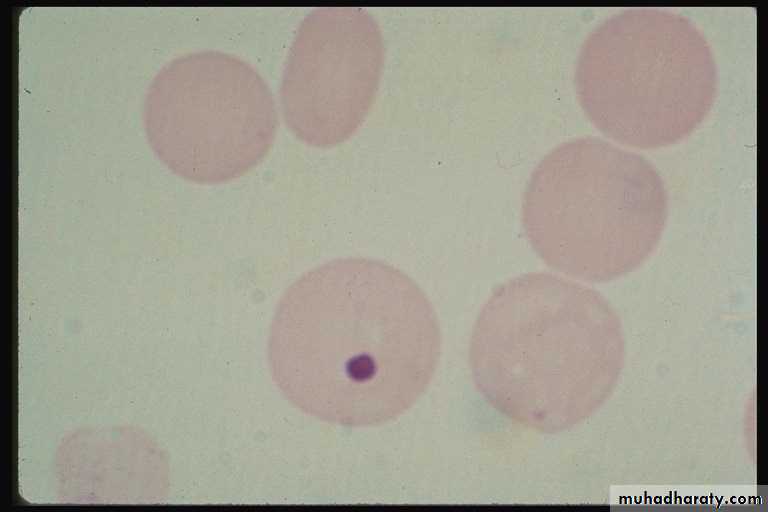
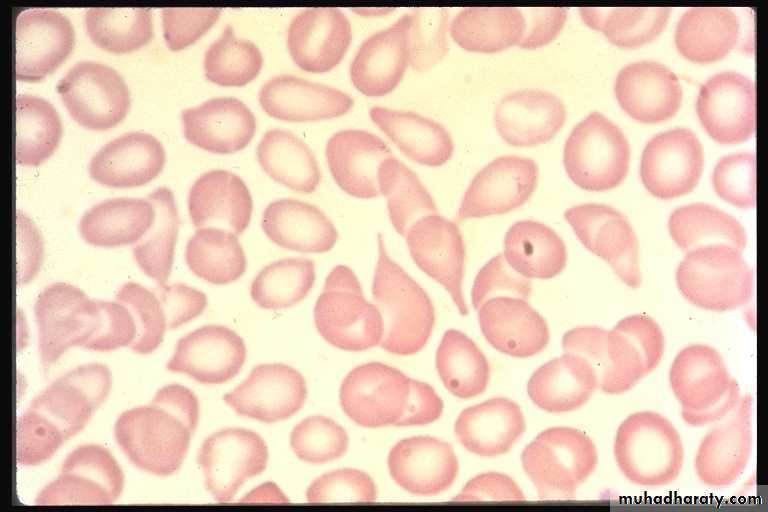

بسم الله الرحمن الرحيم
Introduction of blood disorders
Dr. Bassam Ismael AL-Zuhairi
Internist & medical oncologist
FUNCTIONAL ANATOMY AND HAEMATOPOIESIS
Blood consists of plasma and three cellular components:-red cells, which transport oxygen from the lungs to the tissues
-white cells, which protect against infection
-platelets, which interact with blood vessels and clotting factors to maintain vascular integrity.
Plasma, which contains proteins with many
functions, including antibodies and coagulation
factors.
SITES OF HAEMATOPOIESIS
Haematopoiesis is the process of formation of blood cells. In the embryo this occurs initially in the yolk sac, followed by the liver and spleen; by 5 months in utero, haematopoiesis is established in the bone marrow.Under pathologic conditions that stress the capacity of the marrow space, as seen in diseases associated with marrow fibrosis (myeloproliferative diseases) or in severe inherited hemolytic anemia (thalassemia major), extramedullary hematopoiesis may be reestablished in sites of fetal hematopoiesis, especially the spleen.
. At birth, haematopoietic (red) marrow is found in the medullary cavity of all bones, but with age this is progressively replaced by fat (yellow marrow) so that by adulthood, haematopoiesis is restricted to the vertebrae, pelvis, sternum, ribs, clavicles, skull, upper humeri and proximal femora. Bone marrow usually accounts for 5% of an adult's weight but red marrow can expand in response to increased demands for blood cells.
Haematopoietic cells are set in and interact closely with a connective tissue stroma made of reticular cells, macrophages, fat cells, blood vessels and nerve fibers. This stroma provides the suitable microenvironment for blood cell growth and development.
Stem cells
All blood cells are derived from a pluripotent stem cell (CD34) which has the ability to self-renew (make more stem cells) and to differentiate to form any of the blood elements. It has the appearance of a small or medium-sized lymphocyte. These comprise only 0.01% of the total marrow cells:-CFU-GM (colony-forming unit-granulocyte, monocyte) is a stem cell that produces granulocytic and monocytic lines.
-CFU-E produces erythroid cells
- CFU-Meg produces megakaryocytes and ultimately platelets
The proliferation and differentiation of stem cells and their progeny are under the control of a range of growth factors produced by several cells, including stromal cells and lymphocytes e.g. granulocyte macrophage-colony stimulating factor (GM-CSF), interleukin-3 (IL-3) and stem cell factor (SCF), erythropoietin (Epo), granulocyte-colony stimulating factor (G-CSF) and thrombopoietin (Tpo).
Recent evidence suggests that the bone marrow contains stem cells which can differentiate into cells from tissues other than the blood, such as nerve, skeletal muscle, cardiac muscle, liver and blood vessel endothelium. This is termed stem-cell plasticity and may have exciting clinical applications in the future.
Stem cell division and same. A – stem cells; B – progenitor cell; C – differentiated cell; 1 – symmetric stem cell division; 2 – asymmetric stem cell division; 3 – progenitor division; 4 – terminal differentiation
Red cells
Red cell precursors formed from the erythroid progenitor cells are called erythroblasts or normoblasts.The first non-nucleated red cell is a reticulocyte which still contains ribosomal material in the cytoplasm, stained with a faint blue tinge, termed polychromasia. Reticulocytes lose their ribosomal material and mature over 3 days.
Red cell production is controlled by erythropoietin, a polypeptide hormone produced by renal tubular cells in response to hypoxia
WBC
The first recognisable granulocyte in the marrow is the myeloblast
WBC may be freely circulating or attached to endothelium in the marginating pool. These two pools are equal in size; factors such as exercise or catecholamines increase the cells flowing in the blood, so increasing the white cell count.
Neutrophils spend 6-10 hours in the circulation before being removed, principally by the spleen.
Eosinophils are phagocytic and their granules contain a peroxidase capable of generating reactive oxygen species and proteins involved in the intracellular killing of protozoa and helminths. They are also involved in allergic reactions (e.g. atopic asthma).
Basophils are less common than eosinophils, representing less than 1% of circulating white cells. Mast cells resemble basophils but are found only in the tissues. These cells are involved in hypersensitivity reactions .
Monocytes are large cells derived from monoblasts. These cells circulate for a few hours and then migrate into the tissues where they can mature into macrophages Kupffer cells or antigen-presenting dendritic cells.
There are two main types of lymphocytes: T cells (which mediate cellular immunity, 80% of circulating lymphoid cells) and B cells (which mediate humoral immunity). Lymphoid cells which migrate to the thymus develop into T cells, whereas B cells develop in the bone marrow.
Platelets
Platelets are derived from megakaryocytes.Up to 3000 platelets then fragment off from each megakaryocyte into the circulation in the marrow sinusoids.
The formation and maturation of megakaryocytes are under the influence of Tpo(thrombopoietin), a recombinant form of which is in clinical use.
Platelets circulate for 8-14 days before they are destroyed in the reticulo-endothelial system. Some 30% of peripheral platelets are normally pooled in the spleen and do not circulate.
INVESTIGATION OF DISEASES OF THE BLOOD
• THE FULL BLOOD COUNT :Hb, PCV, WBC, red cell indices which give information about the size of red cells (mean cell volume, MCV) and the amount of haemoglobin present in the red cells (mean cell haemoglobin, MCH)
• -Modern blood analysers can detect the different types of white blood cell and give automated white cell differential counts including neutrophils, lymphocytes, monocytes, eosinophils and basophils. It is important to appreciate, however, that a number of conditions can lead to spurious results
NORMAL VALUES FOR PERIPHERALBLOOD CELLS
SPURIOUS FBC RESULTS FROM AUTOANALYSERS
Lipaemia, jaundice, very high white cell countIncreased haemoglobin
Improper sample mixing, blood taken from vein into which an infusion is flowing
Reduced haemoglobin
Cold agglutinins, non-ketotic hyperosmolarity
Increase MCV
Nucleated red cells present
Increase WBC
Clot in sample, platelet clumping
Reduced platelet count
2. BONE MARROW EXAMINATION
Sites: posterior iliac crest, ant iliac crest, sternum.
Morphpolgy, immunophenotyping, chromosome and molecular studies to assess malignant disease, or marrow culture for suspected tuberculosis.
Neutropenia
Infection: viral, bacterial (e.g. Salmonella), protozoal (e.g. malaria)• Drugs
• Autoimmune: connective tissue disease
• Alcohol
• Bone marrow infiltration: leukaemia, myelodysplasia
• Congenital: Kostmann’s syndrome
• Constitutional: Afro-Caribbean and Middle Eastern descent
Mild (1000 to 1500/μL)
Moderate (500 to 1000/μL)Severe (< 500/μL)
NEUTROPHILIA
• Infection: bacterial, fungal
• Trauma: surgery, burns
• Infarction: myocardial infarct, pulmonary embolus, sickle-cell crisis
• Inflammation: gout, rheumatoid arthritis, ulcerative colitis, Crohn’s disease
• Malignancy: solid tumours, Hodgkin lymphoma
• Myeloproliferative disease: polycythaemia, chronic myeloid leukaemia
• Physiological: exercise, pregnancy
Lymphocytosis
Infections: infectious mononucleosis[3] (glandular fever), hepatitis and CMV, pertussis, toxoplasmosisTB, BRUCELLOSIS
CLL
Eosinophilia
Allergic diorders: asthma, hay fever, skin disease, drugs allergy.Parasitis inf.
SLE
Lymphoma, ovarian tumor
Hypereosinophilic syndrome
Spherocytosis :1. H. spherocytosis2. Autoimmune hemolysis
RETICULOCYTE COUNT
0.2 to 2.0%= 10,000 to 100,000/uL
(Adults & Children)
2.0 to 6.0%
Mean = 150,000(Infants/ Cord Blood)
Normal morphology
Target cells (codocyte):1. Liver disease 2.Thalassaemia 3. Post-splenectomy
PATHOLOGICAL RBC ABNORMALITIES
Sickle Cells(drepanocyte)Burr cells(renal failure)
PATHOLOGICAL RBC ABNORMALITIES
Acanthocytosis-liver disease
abetaliporoteinemia
PATHOLOGICAL RBC ABNORMALITIES
SCHISTOCYTOSIS
MAHA
PATHOLOGICAL RBC ABNORMALITIES
STOMATOCYTOSISPATHOLOGICAL RBC ABNORMALITIES
HOWELL JOLLY bodies (small round nuclear remnants)Hyposplenism
• Post-splenectomy
PATHOLOGICAL RBC ABNORMALITIES
TeardropRed cells
(dacrocyte)
Liver disease
• Thalassaemia
• Post-splenectomy
• Haemoglobin C disease
ESR
is a sensitive, but nonspecific, indicator of inflammation
INCREASE IN:
• Anemia
• Pregnancy
• CTD
• Mailgnancy
• Tb
• giant cell arteritis
• polymyalgia rheumatica
• Infective endocarditis
• Rheumatic fever
ESR > 100 mm/hr
Vasculitis
Giant cell arteritis
Polymyalgia rheumatica
Waldernstrom macroglobulinemia
Chronic infections
Metastatic cancer
Multiple myeloma
Approach to anemic patient
Is patient is anemicRet. Count
2 corrections• cRet= measured Ret *(pt pcv/45)
• e.g. In a person whose reticulocyte count is 9%, hemoglobin 7.5 g/dL, hematocrit 23%, the absolute reticulocyte count = 9 x (7.5/15) [or x (23/45)]= 4.5%
3. MCV?
low(microcytosis):1.IDA 2. Thalassemia 3. ACD 4. sideroblastic anemiaNormal( nomocytic): ACD, early IDA, Aplastic A
High (macrcytic): megaloblastic A, non-megaloblastic A.
2. Reticulocyte production index (RPI)= cRet/ correction factor
If RPI< 2 Inadequate BM response (hypoproliferative anemia)
If RPI>2 adequate BM response (hyperproliferative anemia)